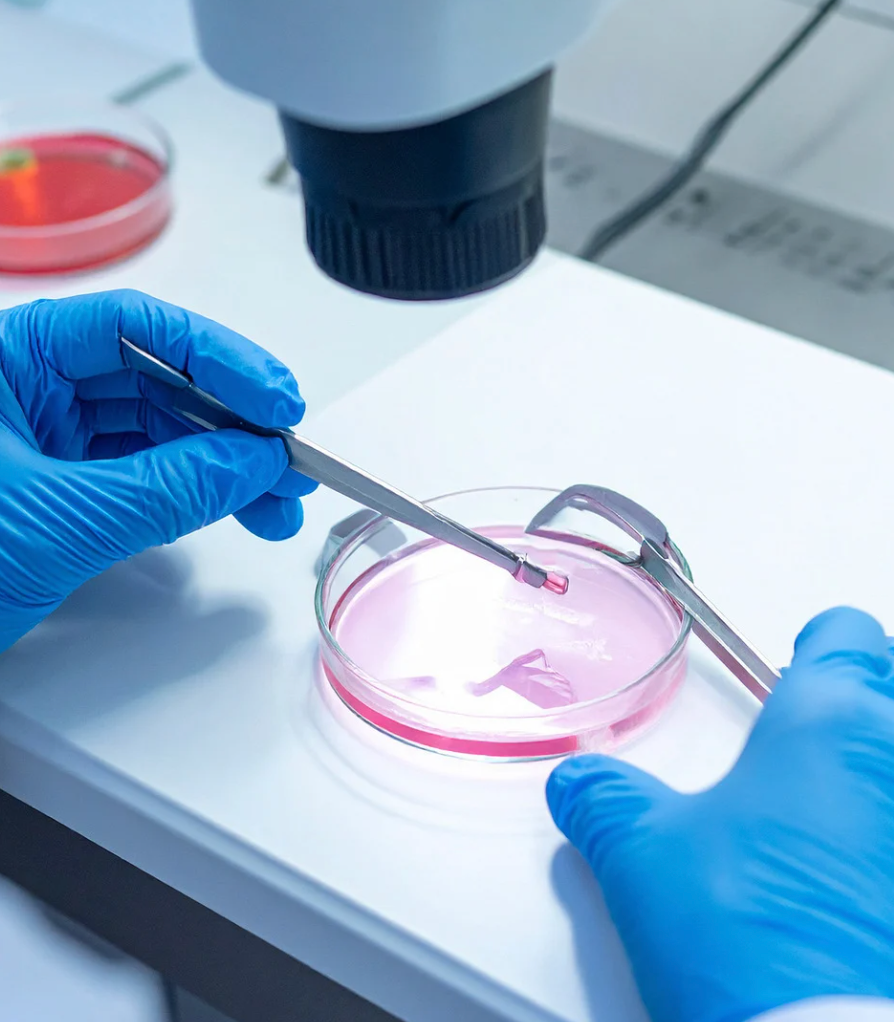
Ovulation

Total Fertility Solution – Best IVF Specialist & Test Tube Baby Center in Indore
Total Fertility Solution is a trusted test tube baby center in Indore offering advanced fertility treatments for couples who want to start their parenthood journey. With experienced doctors, modern fertility labs, and personalized care, we are recognized as one of the ivf best hospital in Indore for successful fertility treatments.
Our center is led by the best IVF specialist Indore, providing compassionate guidance and advanced reproductive technologies to help couples overcome infertility challenges. From initial diagnosis to complete fertility treatment, we ensure every patient receives the highest standard of care.
Advanced IVF Treatment in Indore
At Total Fertility Solution, we provide world-class IVF treatment in Indore using the latest reproductive technologies and advanced laboratory systems. IVF (In-Vitro Fertilization) helps couples who are struggling with infertility due to various medical conditions such as blocked fallopian tubes, ovulation disorders, male infertility, or unexplained infertility.
Our fertility experts carefully design personalized treatment plans to increase the chances of successful pregnancy. This commitment to patient care makes us one of the most trusted centers for IVF treatment in Indore.
Expert ICSI Treatment in Indore
For couples facing male infertility issues, we offer advanced ICSI treatment in Indore (Intracytoplasmic Sperm Injection). In this procedure, a single healthy sperm is injected directly into the egg to improve fertilization chances.
Our fertility specialists perform ICSI treatment in Indore using high-precision equipment and advanced embryology labs, ensuring the best possible outcomes for couples struggling with male factor infertility.
IVF Treatment – What We Offer
At Total Fertility Solution, our IVF treatments are carefully designed to address a range of fertility challenges, including:
- Low sperm count or motility
- Blocked fallopian tubes
- Ovulation disorders
- Endometriosis
- Unexplained infertility
Why Choose Total Fertility Solution for IVF in Indore?
Infertility can be a challenging and emotional journey. Choosing the right fertility clinic makes all the difference.
- Experienced IVF Specialists – Our team, led by Dr. Shivani Joshi (Infertility Specialist) and Dr. Sankalp Joshi (Urologist Specialist), brings years of experience.
- Comprehensive Fertility Services – From initial consultation and diagnosis to advanced reproductive techniques.
- Patient-Centric Approach – Each treatment is tailored to your specific needs.
- Advanced Technology – We use modern IVF and ICSI labs equipped with research-grade tools.
- High Success Rates – Our rigorous protocols help couples realize their dream of parenthood.

.jpg)

.jpg)